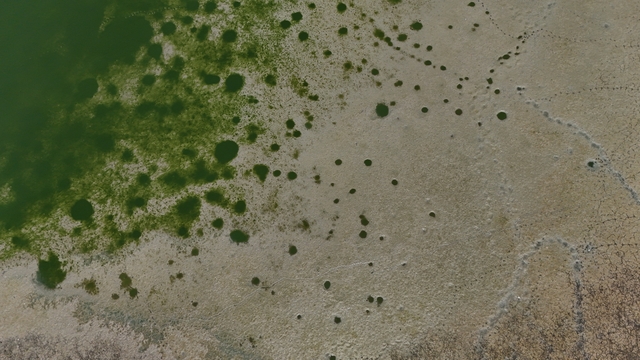
Galeri

Kırklareli'nin Oruçlu Göleti kuraklık nedeniyle kuruma noktasına geldi
Kırklareli'nin Babaeski ilçesindeki Oruçlu Göleti, kuraklık nedeniyle kuruma noktasına geldi.

Kırklareli'nin Babaeski ilçesindeki Oruçlu Göleti, kuraklık nedeniyle kuruma noktasına geldi.
İlçeye bağlı Oruçlu köyündeki sulama göletinin su seviyesi, haziran ayından itibaren etkili olan aşırı sıcaklık nedeniyle düşmeye başladı.
Kuruma noktasına gelen göletteki balıklar da yaşam mücadelesi veriyor.
Merada otlayan hayvanların su içmesi amacıyla kullanılan gölette suyun çekildiği bölgelerde ise çatlaklar oluştu. Çok sayıda kuşun da göldeki balıkları kolayca avladığı gözlendi.
Anadolu Ajansı ve DHA tarafından geçilen tüm Kırklareli haberleri, bu bölümde Haberturk.com editörlerinin hiçbir editoryal müdahalesi olmadan otomatik olarak ajans kanallarından geldiği şekliyle yer almaktadır. Kırklareli Haberleri alanında yer alan haberlerin hepsinin hukuki muhatabı haberi geçen ajanslardır.